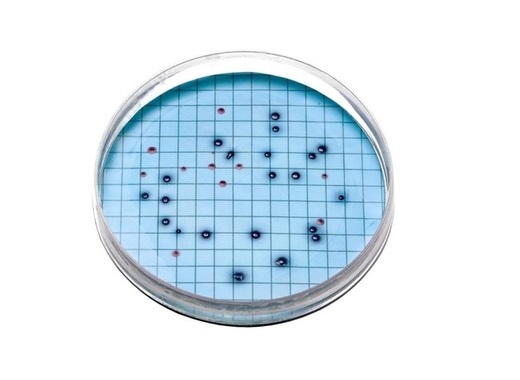
...

Media for Presence/Absence test (MUG), in sterile plastic bottle. 120 pieces (10x pk/12). Presence-absence tests are a convenient way to detect coliforms and E. Coli in your water system.
Read More
Presence/Absence Test with MUG; disposable; pk/50. Presence-absence tests are a convenient way to detect coliforms and E. Coli in your water system. Conforms to Standard Methods 9221D.
Read More
Prepared media for simultaneous detection of E.coli and total coliforms on filter in 24 hours.Simultaneously detect total coliforms and E.coli. No fluorescent lamps or colour comparators required
Read More
In 24 hours, Hach's m-ColiBlue24® Broth give you simultaneous results for total coliforms and E. coli. Hach's ready-to-use media eliminates measuring, mixing, and autoclaving steps necessary to prepare dehydrated media.
Read More
Pseudomonads BART Test, Slime-Forming Bacteria. BART biodetectors are excellent diagnostic tools to help identify the presence of process disruptors, such as bacteria creating slime layers and limiting disinfection.
Read More
The paddle is a double-sided slide attached to the vial cap. Each side of the slide is used to perform a separate test. The slide has a molded-in grid for easy colony counting without opening the optically clear, leakproof vial.
Read More
Tryptic Soy Agar/Violet Red Bile Agar: Save time and simplify lab and field testing with Hach prepared P/A media; Report Total Coliform values with EPA accepted Presence-Absence bottles and media.

Presence/Absence test for coliforms; Disposable; pk/12. • Complete Solutions for Testing Recreational Water • Complete Solutions for Testing Wastewater • Complete Solutions for Testing Drinking Water

Glass ampules (26084-20), plastic ampules (260845-00), 100mL bottles (26084-42) of m-ColiBlue24® and agar plates (28052-15), afford maximum shelf life and ease of use for pre-measured and prepared media.
Read More
The HPC is a procedure for estimating the number of live heterotrophic bacteria in water. The HPC is useful in judging the efficiency of various treatment processes for both drinking water and swimming pools
Read More
For detection of Pseudomonas species. pk/50. • Complete Solutions for Testing Recreational Water • Complete Solutions for Testing Wastewater • Complete Solutions for Testing Drinking Water
Read More
m-Endo Broth, pk/50 2-mL ampules (plastic). Selectivity: Total Coliform Bacteria and Escherichia coli. m-Endo broth detects total coliform bacteria (colonies with a greenish-gold sheen).
Read More
m-Endo broth, 2 mL ampules (glass), 20 pieces. Complete solutions for testing recreational water, waste water and drinking water
Read More
Polystyrene Petri dish, w/pad (PALL), 100/pk. Disposable Petri dishes for 2 mL Broth media and Ø 47 mm membrane filter
Read More
Sampling bag, sterile with dechlorinating agent,100 pcs. Contains non-nutritive pill with 10mg sodium thiosulfate four 100mL fill-lines.
Read More
The Total Coliform MEL Laboratory is designed for analysts who need portable or small-scale microbiology testing capabilities
Read More